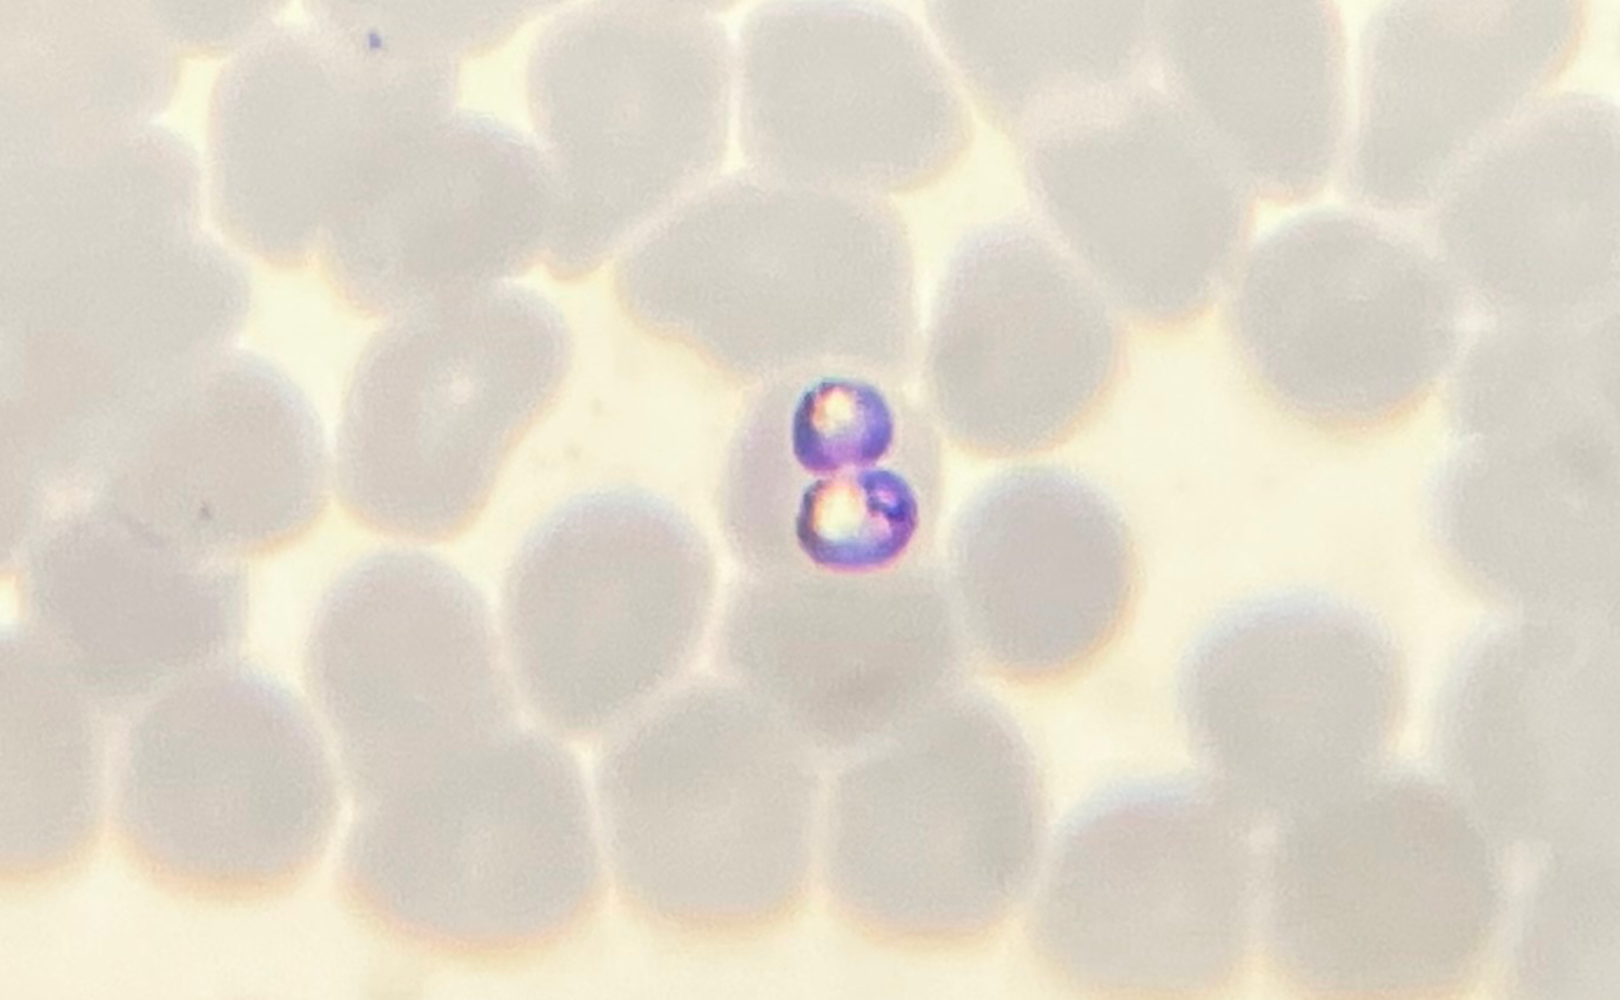
Mikroskopisk billede af flere blege, runde blodlegemer med en centralt placeret celle, der viser to lilla farvede cirkulære strukturer, som muligvis indikerer en parasit inde i et rødt blodlegeme.

Hvordan går det egentlig med den globale opvarmning?
Hvor hurtigt stiger temperaturen globalt og herhjemme? Hvor i verden kommer CO2-udledningen egentlig fra? Og hvilke lande har sat sig de mest ambitiøse klimamål?
Alt det kan du få overblik over herunder, hvor vi har samlet de vigtigste grafer, der løbende opdateres og viser, hvordan det går i kampen mod klimaforandringer.
\ Om graferne
Graferne stammer hovedsageligt fra organisationen Our World in Data, som forskere fra University of Oxford står bag.
Mange af graferne er interaktive, så du kan trykke på dem for at se nærmere på bestemte lande og regioner, justere tidslinjer og klikke på 'Sources' for at læse mere om, hvor data stammer fra.
Tips:
- Mange af graferne er interaktive, så du kan trykke på dem og udforske data.
- Mobilbrugere kan med fordel vende skærmen på siden, så graferne bliver større.
Temperaturen stiger
Vi begynder med den allervigtigste graf, der viser udviklingen i den globale middeltemperatur - her sat i forhold til gennemsnittet i perioden 1961-1990.
Temperaturen er de seneste årtier steget skarpt, og det er nu 1,1 grader varmere, end det var, før industrialiseringen tog fart i 1850.
Stigningen sker også i Danmark
Temperaturen er også steget herhjemme i Danmark, hvor år 2020 var 1,5 grader varmere end gennemsnittet i perioden 1981-2010.
Det viser 'klimastriberne' herunder. De blå farver betyder kolde år, mens de varme er røde.
Landområder og Arktis opvarmes mest
Temperaturen har været stigende over stort set hele kloden, men den største stigning er sket over land og i de arktiske egne.
Det illustrerer det store verdenskort herunder, hvor FN's klimapanel har farvelagt de observerede lokale temperaturændringer, da den globale opvarmning nåede 1 grad.
Jo rødere området er, des varmere er det blevet.
De tre mindre kort viser forudsigelser af, hvordan temperaturen vil stige i forskellige egne af verden, hvis den globale opvarmning når op på henholdsvis 1,5 grader, 2 grader eller 4 graders stigning.

Opvarmningen er ekstrem og skyldes mennesker
FN's klimapanel IPCC udgav i august 2021 en monumental rapport, som samlede op på viden fra 14.000 klimastudier. De to grafer på billedet herunder stammer fra den rapport.
Grafen til venstre viser resultatet af beregninger og observationer af, hvordan klodens middeltemperaturer har udviklet sig de seneste 2.000 år. Den brat stigende kurve tydeliggør, at de seneste årtiers opvarmning sker meget hurtigt og til unormale højder.
Et spørgsmål har været, i hvor høj grad opvarmningen sker på grund af menneskers aktivitet, og det har klimapanelets rapport givet et klart svar på, hvilket ses i grafen til højre, hvor der er zoomet ind på perioden efter 1850, hvor industrialiseringen tog fart.
Stort set hele den observerede opvarmning i den periode skyldes menneskelig aktivitet. Havde det kun været for naturlige faktorer såsom Solens stråling og vulkansk aktivitet, havde temperaturerne i dag været stabile på samme niveau som i 1850.

Koncentrationen af CO2 i atmosfæren stiger
Opvarmningen skyldes menneskers udledning af drivhusgasser.
\ Drivhusgasser
Drivhusgasser såsom kuldioxid, metan og lattergas hænger i atmosfæren og holder igen på udstrålingen af energi fra Jorden. Med andre ord giver de Jorden en isolerende effekt kaldet drivhuseffekten. Gasserne fungerer altså lidt som en dyne - og jo flere gasser, des tykkere 'dyne' er der omkring Jorden.
Koncentrationen af drivhusgasserne kuldioxid (CO2), metan og lattergas er stigende, og stigningen tog fart i takt med industrialiseringen i midten af det 19. århundrede.
- CO2-koncentrationen lå i tusindvis af år før 1850 på cirka 280 ppm (ppm står for 'parts per million' - på dansk 'dele per million').
- I 2021 er koncentrationen af CO2 i atmosfæren 417 ppm og stadig stigende.
Ved at studere iskerneboringer kan forskere se, at koncentrationen af CO2 de seneste 800.000 år aldrig har været så høj som nu, hvilket du kan se på grafen herunder, hvis du trykker på 'long-run series' i bunden.
Vi har kurs mod yderligere opvarmning
Næsten alle verdens lande blev med Parisaftalen i 2015 enige om at holde temperaturstigningen et godt stykke under 2 grader - og at stræbe mod at begrænse opvarmningen til 1,5 grader.
Som det ses af grafen herunder, kræver det, at udledningerne af drivhusgasser sænkes drastisk i de kommende år (de gule og grønne kurver).
Landenes nuværende klimapolitikker lever dog ikke op til målet, og de vil føre til en temperaturstigning på mindst 2,7 grader i år 2100 over det førindustrielle niveau. Det viser en analyse kaldet 'Climate Action Tracker', som løbende følger landenes tiltag og beregner effekterne af dem.
Forudsigelserne er lavet med en klimamodel og indebærer derfor usikkerheder. En FN-rapport kom dog forud for klimatopmødet COP26 også frem til, at en temperaturstigning på 2,7 grader i år 2100 er det mest sandsynlige scenarie ud fra de løfter og mål, landene indtil videre har sat sig.

Isen smelter
En af de meget synlige konsekvenser ved den globale opvarmning er, at isen på Jorden smelter.
Med satellitter har NASA siden 1979 kunnet se, hvordan den arktiske havis er blevet mindre og mindre. Hver sommer smelter havisen, men i 80'erne var der selv i smeltesæsonen altid mindst 6 millioner kvadratkilometer tilbage. I 2020 var havisens minimumsudbredelse nede på 3,36 millioner kvadratkilometer.
Det kan du se i videoen her:
Havet stiger
En anden konsekvens er stigende havniveau. Vandstanden stiger, fordi gletsjere og indlandsis smelter og løber ud i havet, og fordi varmen får havet til at udvide sig. Ifølge den seneste klimarapport fra FN's klimapanel er vandstanden ikke steget så hurtigt som nu de seneste 3.000 år.
Ifølge rapporten vil vi i bedste fald se havstigninger på 30-50 centimeter i dette århundrede, mens havet kan stige med over 1 meter frem mod 2100 i de værste scenarier.
Rapporten konkluderer også, at en stigning i den globale opvarmning på 2 grader med høj sandsynlighed vil betyde flere vejrekstremer såsom mere kraftig regn og oversvømmelser, værre tørker og hårdere hedebølger. Læs mere om konsekvenserne for både mennesker og natur i artiklen 'Der er kæmpe forskel på, om temperaturen stiger med 1,5 eller 2 grader'.
I grafen her kan du se, hvordan klodens gennemsnitlige havniveau er steget siden 1880:
Hvor kommer udledningerne fra?
Energiproduktion forårsager tre fjerdedele af verdens menneskeskabte drivhusgasudledninger. Landbrug og fødevareproduktion udgør også en markant del, og herfra udledes også metan og lattergas.
Tryk på cirkeldiagrammet herunder for at dykke ned i, hvor stor en andel af verdens samlede drivhusgasudledninger de forskellige sektorer står bag.
De efterfølgende statistikker fokuserer på udledningen af CO2, der er den vigtigste drivhusgas på langt sigt. Vil du vide mere om metan, der er en meget potent drivhusgas på kort sigt, så læs artiklen 'Drivhuseffekten: Behøver vi at bekymre os om metan?'
Hvem står bag CO2-udledningerne?
Historisk set har Europa og USA stået for den største udledning af CO2, men de seneste årtier er lande i Asien, særligt Kina, begyndt at fylde mere og mere i verdens CO2-regnskab.
Bemærk, at grafen herunder kun omfatter CO2, som er udledt via cementproduktion og fossile brændstoffer. Faktorer som skov- og landbrug er altså ikke indregnet.
Vi bliver flere og flere mennesker
En del af forklaringen på den stigende CO2-udledning er, at vi bliver flere og flere mennesker på Jorden. Befolkningstilvæksten har været kraftigst i Asien.
FN forudsiger, at væksten først flader ud omkring år 2100, hvor der i alt vil være 11 milliarder mennesker på kloden.
Folk i rige lande udleder mest
CO2-udledningen har også historisk hængt sammen med landenes levestandard. Australien, Saudi Arabien og rige, vestlige lande har nogle af de højeste CO2-aftryk per indbygger, mens eksempelvis et uland som Indien stadig ligger forholdsvis lavt per indbygger.
Det kan du se i nedenstående kort, der illustrerer landenes forbrugsbaserede CO2-udledninger per indbygger.
Udledningen falder i Danmark
I takt med at levestandarden er steget i nogle lande såsom Kina og Indien, er CO2-udledningen også vokset de steder.
I mange vestlige lande er udledningen til gengæld faldet. Det gælder eksempelvis i Danmark, som du kan se på nedenstående graf.
Tallene afslører dog også, at faldet har været størst på den produktionsbaserede udledning.
Faldet er ikke helt så stort, når man ser på den udledning, som danskernes forbrug skaber . Den forbrugsbaserede udledning medregner nemlig CO2-aftrykket for de varer, som bliver importeret fra andre lande.
Fossile brændsler skaber CO2-udledningen
Forbruget af energi er stigende på verdensplan, og det er især afbrændingen af kul, olie og gas, der forårsager verdens CO2-udledninger.
Olie udleder mest CO2 i Danmark
Generelt er CO2-udledningen fra fossile brændsler faldet i Danmark, hvor olie står bag den største del.
Med til regnestykket hører dog også, at danske kraftvarmeværker er blevet omstillet til at fyre med biomasse. Det er meget omdiskuteret, blandt andet fordi en del af biomassen er træer, der bliver importeret fra Rusland og USA, og træfældning kan medføre, at skove lagrer mindre CO2, hvis der ikke plantes nye træer, i samme hast som der fældes.
Grøn energi vinder frem
For at sænke CO2-udledningerne skal landene gå bort fra fossile brændsler, og omstillingen til energi med lave CO2-udledninger er i gang i mange lande.
Kortet herunder viser, hvor stor en andel af landenes energiforsyning, der kommer fra atomkraft og vedvarende kilder såsom biomasse, vind-, sol-, vand-, bølge- og geotermisk energi.
Landenes mål om at blive CO2-neutrale
Som vist ovenfor, er landenes tiltag dog ikke nok til at nå Parisaftalens mål om at holde opvarmningen et godt stykke under 2 grader i forhold til det førindustrielle niveau.
Derfor slutter vi af med nedenstående kort, der sætter fokus på, hvor langt landene er med at indføre klimapolitik, der skal bringe deres nettoudledning af CO2 ned på nul.